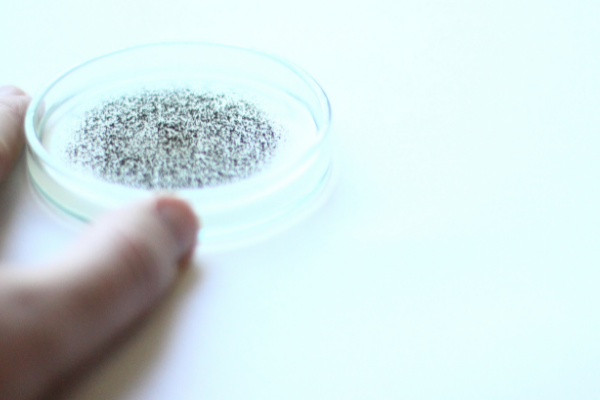

Sommario
Le impurità sulla pelle sono particolarmente sgradevoli quando fanno male (a causa di un'infiammazione), bruciano o lasciano cicatrici. Questi imperfezioni possono sorgere anche sul décolleté o sulla schiena.
E cosa fai per togliere i brufoli?

Ti rivolgi alla prima farmacia, riempi il cestino di cosmetici per la cura della pelle e la pulizia e speri il miracolo. Forse sei stato anche abbastanza fortunata da scegliere prodotti che ti hanno aiutato a ridurre l'infiammazione e rimuovere le impurità. Ma dopo un po', forse già il mese prossimo, sono tornati.
Se anche tu stai girando in un circolo vizioso, è il momento di approfondire cosa sta realmente accadendo quando i problemi della pelle si manifestano durante il giorno. Ma prima diamo un'occhiata a quali sono i problemi della pelle più comuni.
I problemi della pelle più comuni
D’accordo del tipo di problema, che stai affrontando, puoi scoprire cosa sta realmente succedendo nel tuo corpo.
Acne e brufoli
È comune avere la sensazione di una pelle "sporca", ma non è così. Sciacquare la pelle molte volte al giorno non ti aiuterà. Questo è un segno di un disturbo ormonale e di un intestino, che non riesce a svolgere il suo lavoro. Se non riesci a liberarti di tutte le tossine attraverso l'intestino, questo si manifesterà sicuramente sulla pelle. Allo stesso tempo, l'intestino ha un impatto maggiore sulle cellule T della pelle (lo strato più profondo della pelle che fornisce protezione).
Eczema
È un fenomeno in cui le proteine vengono escrete attraverso la pelle. Il chiamato anche dermatite, è un'infiammazione della pelle direttamente correlata alla "permeabilità intestinale”. L’infiammazione nell’intestino compromette la barriera intestinale, permettendo a particelle di cibo non digerito (proteine, ma anche tossine e altre sostanze) di tornare nel flusso sanguigno.
Rosacea
È dimostrato, che esiste uno stretto legame tra il fungo candida e la rosacea. La candida vive nell'intestino e si nutre di zuccheri e carboidrati semplici. La crescita eccessiva di candida provoca moltissimi problemi come: vaginite fungina, gonfiore, esaurimento e, naturalmente, problemi della pelle.
Psoriasi, malattia autoimmune della pelle
Come ogni malattia autoimmune, anche la psoriasi è un segno, che il corpo attacca sé stesso. Succede quando il sistema immunitario, che si trova nell'intestino, per errore decide di attaccare la pelle. È stato dimostrato, che lo scorretto funzionamento dell’intestino influenza lo sviluppo di alcune malattie della pelle come la psoriasi.
Il detto che la bellezza della pelle viene dall'interno è vero!
Facciamo chiarezza ...
Se mangi troppe caramelle, il giorno dopo hai un'epidemia di brufoli.
Poco prima delle mestruazioni, la tua pelle è piena di brufoli, arrossamenti e macchie.
Durante il periodo degli esami o durante un lavoro duro e importante, quando sei sotto molto stress, non solo il tuo viso è pieno di impurità, ma i problemi si spostano anche sul décolleté e viceversa.
Lo hai notato?
La tua pelle è lo specchio della salute di tutto il corpo. Tutto ciò che accade nel tuo corpo si manifesta sulla tua pelle. In realtà, questo non è insolito, in quanto la pelle è l'organo più visibile e più grande del nostro corpo e in questo modo mostra che qualcosa è fuori equilibrio.
Ma perché sta succedendo questo?
Come comunica l'intestino con la mia pelle?
Conosci il consiglio per una pelle abbronzata più bella? Bevi il succo di carota. Bene, se lo bevi troppo, la tua pelle sarà effettivamente arancione, come se visitassi un solarium troppo spesso. Quindi la carota è molto vivida nel capire come l'intestino influisce sulla pelle.

Nell’intestino risiede più del 70% delle cellule del sistema immunitario. Diversi funzioni dipendono di questo importante organo: l’equilibrio ormonale, la digestione degli alimenti, l’assorbimento delle vitamine e minerali e la produzione dell'ormone della felicità! Il microbiota intestinale è importantissimo, per questo l’intestino è conosciuto come il secondo cervello.
I batteri intestinali influiscono sul nostro organismo! Li dividiamo in buoni, cattivi e neutrali. Purtroppo, oggi è molto comune soffrire di un’alterazione della flora batterica intestinale. La crescita eccessiva di batteri cattivi, conosciuta come disbiosi, può provocare malattie ed infiammazioni croniche.
L'infiammazione è una delle principali cause delle imperfezioni della pelle
L'infiammazione è un meccanismo di difesa dell'organismo, può essere classificata in acuta e cronica. Esistono 2 tipi di infiammazione: acuta e cronica. Sicuramente sei ben consapevole delle condizioni infiammatorie, come dell’infiammazione della mucosa che riveste i seni nasali, conosciuta come sinusite; dell’infiammazione della pelle, dopo una ferita; o della condizione infiammatoria della vescica, conosciuta come cistite. Ma queste sono infiammazioni con sintomi evidenti, come il dolore. Tuttavia, le condizioni infiammatori sono molto più di questo e purtroppo sono l'origine di tutte le malattie.
-(800-x-1600-px).png?v=1633514357224)
8 consigli per ridurre le infiammazioni nel corpo
La preoccupazione per ridurre l'infiammazione è importante non solo a causa delle imperfezzioni della pelle, ma anche perché l'infiammazione cronica può portare a gravi malattie. C'è molto che puoi fare per ridurre l'infiammazione, il primo passo è seguire uno stile di vita e fare cambiamenti nella tua alimentazione.
Mangia cibi antinfiammatori
Sostituisci gli spuntini spazzatura con frutti di bosco o noci e, a pranzo o a cena, mangia broccoli, avocado, pesce azzurro ricco di omega 3, verdure a foglia verde o barbabietole. Puoi anche mangiare cioccolato fondente, che e’ ricco di antiossidanti (ma con moderazione, ovviamente).

Elimina i cibi trasformati dalla tua dieta
Se non l'hai già fatto, ora è il momento di dire addio ai cibi trasformati, carboidrati raffinati e cibi ricchi di grassi trans. Ciò include tutti i cibi fritti, i salumi e le carni lavorate, tutte le bevande dolci e gassate e gli snack.

Fai esercizio regolarmente
L'esercizio e l'attività fisica non sono solo buoni per la formazione del corpo, ma anche per la regolazione degli ormoni e il benessere generale. Ogni giorno hai bisogno di almeno 30 minuti di qualche esercizio come yoga, stretching, ciclismo e 3 volte alla settimana devi fare un'attività fisica più intensa. Combina il divertimento con l'attività fisica, puoi fare un'escursione a piedi sulle colline oppure considera di visitare una palestra nelle vicinanze.

Dormi bene, ogni notte
Puoi morire prima per non dormire, che per non mangiare. Il sonno è uno dei fattori più importanti per la nostra sopravvivenza e benessere. Ogni processo, che si svolge nel corpo, dipende dal sonno. Di notte, il livello di cortisolo diminuisce, tutti i processi ormonali si bilanciano e il corpo si ripristina. Cerca almeno di addormentarti prima di mezzanotte e di dormire profondo per almeno 7 ore.

Di addio alle cattive abitudini
Il fumo e l'alcol non servono danneggiano la nostra salute. Oltre ad aumentare il rischio di molte malattie, ci sono anche 2 delle cause principali di sviluppare infiammazioni nel corpo. Evita il fumo e l’alcol.

Regola lo stress
L'ormone dello stress, cortisolo, aiuta il tuo corpo a controllare e ridurre l'infiammazione quando ti ammali. Può farlo se le tue ghiandole surrenali funzionano bene. Se i livelli di cortisolo non sono ottimali, questo si manifesta in un sistema immunitario indebolito e di conseguenza sorgono malattie acute o croniche. Pertanto, al fine di ridurre le condizioni infiammatorie, è necessario occuparsi della gestione dello stress. Utilizza tutti i giorni qualche tecnica di rilassamento come meditazione, yoga, esercizi di respirazione o massaggi. Fai qualche passeggiata in natura.

Prenditi cura di un microbiota intestinale sano
Se i batteri cattivi superano quelli buoni, c'è caos nell'intestino. Lo squilibrio del microbiota intestinale compromette il tuo benessere, la digestione, il sistema immunitario, l’equilibrio ormonale e può anche provocare infiammazioni nel corpo. Equilibra il microbiota intestinale con l’assunzione regolare di colture microbiche e una dieta varia ed equilibrata.
Aggiungi spezie ed erbe alla tua dieta
Le spezie ed erbe non sono solo ottime da gustare, ma sono considerate un vero tesoro di antiossidanti e sostanze nutritive. Le spezie più efficaci per ridurre le condizioni infiammatorie nel corpo sono: zenzero, cannella, pepe di cayenna, salvia, chiodi di garofano e rosmarino. La curcuma è considerata la regina antinfiammatoria.
Il segreto della curcuma risiede nel principio attivo curcumina, ricca di proprietà antiossidanti e antinfiammatorie, confermate anche da più di 10.000 studi biomedici. Oltre a ridurre con successo l'infiammazione nel corpo, aiuta anche ad alleviare i dolori articolari, regola il colesterolo, supporta la salute della pelle, disintossica il corpo e migliora la funzione cerebrale.
Ecco perché la curcuma non dovrebbe mai mancare in casa.

Fonte:
https://www.ncbi.nlm.nih.gov/pmc/articles/PMC6048199/
https://www.healthline.com/health/red-clover-menopause#drug-interactions






